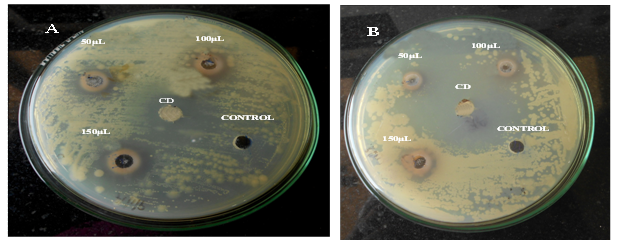
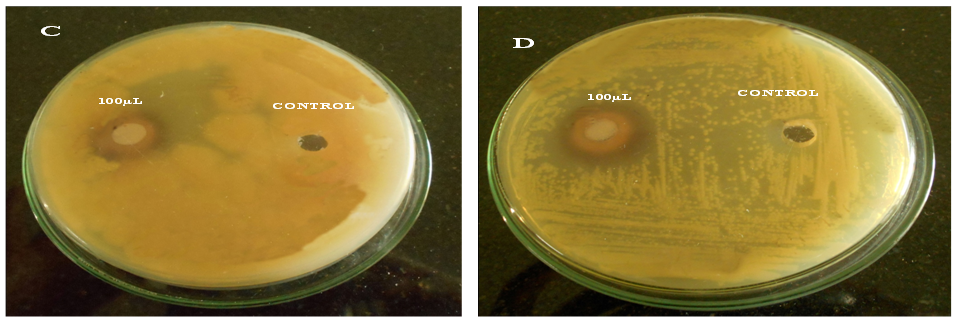

1School of Chemical & Biotechnology, SASTRA University, 2Centre for Advanced Research in Indian Systems of Medicine (CARISM), SASTRA University, India. Email: anusha@scbt.sastra.edu
Received: 23 May 2014 Revised and Accepted: 19 Jul 2014
ABSTRACT
Objective: The present study was designed to evaluate the antimicrobial activity of lyophilized powder of Annona squamosa fruit. Phytochemical screening was carried out to detect the presence of major phytoconstituents.
Methods: Annona squamosa fruit pulps were lyophilized and made into powder, which was diluted with 0.1% DMF. This extract was tested against gram positive and gram negative bacteria employing Agar well diffusion method.
Results: The results showed that fruit extract possess antimicrobial activity against microbial isolates. The antibacterial activity increased with increase in mass of fruit extract, which was evidenced through zone of inhibition. The fruit extract showed significant activity when compared with standard positive antibiotic viz. Chloramphenicol (10 µg /disc). The preliminary phytochemical screening tests confirmed the presence of compounds such as alkaloids, terpenoids, flavonoids, steroids, saponins and glycosides as major constituents.
Conclusion: Based on the results it is concluded that Annona squamosa has good antimicrobial activity against human pathogens and is also rich in phytochemical constituents.
Keywords: Annona squamosa, Antibacterial, Phytochemical screening, Lyophilized fruit powder.
INTRODUCTION
Plants are one of the important sources of traditional medicines. Annona squamosa (Custard Apple) is a well-known fruit for its nutritional composition as well as for its medicinal properties. This fruit is commonly known as custard apple, sugar apple, sweet soup, sour soup and tatatopa.
Custard apple tree is a tropical deciduous tree distributed throughout India. Leaves of Annona squamosa are used to treat ulcer and wounds. Major Phytochemicals present in this fruit are alkaloids, volatile matter, glycosides, flavonoids, long chain fatty acids, steroids, acetogenins, phytosterols, tannins, cyclic ketones, sterpenoids and phenolic compounds.
The edible portion of this fruit contains proteins, fats, carbohydrates, crude fibers, minerals, calcium, phosphorus, iron, magnesium, copper, ascorbic acid, niacin and nicotinic acid. The glycemic index of fruit is low due to its low sugar content. Each and every part of the custard apple tree such as bark, leaf, stem, seed are used for therapeutic purposes [1].
Herbal drugs developed from plants are known for their safety and efficacy as compared to synthetic drugs. In in vivo studies, it was concluded that custard apple seeds were 300 times more effective than Taxol, an anticancer drug [2]. Custard apple fruit is a new super fruit of the 21st century possessing antiobese, antidiabetic, antimicrobial and anticancer properties [3]. Both ethanol and aqueous leaf extracts of Annona squamosa showed good antidiabetic properties in type 1 and type 2 diabetes [4, 5, 6].
Another component of this fruit is acetogenin. The acetogenin compounds are very unique to the Annonacea family, which are likely to have anticancer activity [7]. Pathogenic microorganisms that cause life-threatening infections in humans are increasing worldwide and rate of morbidity due to these infections are also increasing in developing countries. Usage of antibiotics is restricted due to the emergence of antibiotic resistant mutants; hence there is a need to search different or alternative drugs for the treatment of bacterial infections [8].
Plant and plant-derived compounds are alternative sources for treating microbial infections. Fruit extracts of Annona squamosa possess antimicrobial activity without causing side effects [9]. The Phytochemical screening has been reported for methanol, water, chloroform and petroleum ether extracts of Annona squamosa leaves [10]. The preliminary phytochemical screening has been reported for the related species of Annona squamosa like, Annona muricata stem extract [11].
Hence attempts are made in this present study to evaluate the antibacterial efficacy of Annona squamosa. Preliminary phytochemical screening was also carried out for the extract to identify the nature of chemical constituents present.
MATERIALS AND METHODS
Collection of Plant Materials
Fresh fruits of Annona squamosa were collected from NILGIRI’S fruit shop, Thanjavur in the month of December 2013.
Methadology
Collection and Processing of Sample
The fruits were collected manually peeled and seeds were removed. The fruit pulp was divided into two portions. One fraction of the fruit pulp was lyophilized into fine powder and the other part of fruit pulp was used as such. Both these fractions were utilized for preparation of extracts.
Preparation of ethanol and aqueous extracts
For both ethanol and aqueous extraction, about 10g of fruit pulp and lyophilized powder was taken and added to 100 mL of ethanol and 100 mL of distilled water. The sonication done for 30 minutes using these mixtures and left at room temperature overnight. The Whatman No.1 filter paper used for extract filtration and those filtrates were concentrated under reduced pressure to obtain a pasty mass.
Tests for Preliminary Phytochemical Screening
The Phytochemical screening was carried out for both aqueous and ethanolic extracts of lyophilized powder and fruit pulp to detect the presence of various constituents like steroids, terpenoids, alkaloids, glycosides, flavonoids, saponins, carbohydrates, fats & proteins, tannins and phenolic compounds as per standard procedures [12,13,14].
Sample preparation for antimicrobial activity
0.1% DMF was added to lyophilized powder and allowed to dissolve for half an hour and then filtered using whatman filter paper. This fruit extract was subjected for antimicrobial screening.
Microbial strains
Gram positive bacterial strains used were Staphylococcus aureus, Streptococcus pyrogens and Bacillus subtilus, while gram-negative bacterial strains used were, Vibrio cholera, E. Coli, Protease vulgaris, Salmonella typhi, Pseudomonas aeruginosa and Shigella dysentriae, Klebsiella pneumonia.
Preparation of inoculums
The suspension of all organisms were prepared by inoculating one colony of the strain in 30 mL of Muller Hinton broth in conical flask and incubated at 37ºC for 24 hours to activate the strain. Muller Hinton agar (Hi Media) was prepared for the study.
Screening of Antimicrobial activity
Screening for antimicrobial activity of lyophilized fruit powder was carried out against various bacterial organisms using agar well diffusion method. Muller Hinton agar medium prepared was poured into the sterile petri plates and allowed to solidify. Different amounts of lyophilized fruit powder such as 10 mg, 20 mg, and 30 mg were used to screen against different organisms. A standard (Chloramphenicol 10 µg) disc was used as a positive control while 0.1% DMF was used as negative control. Plates were allowed to incubate at 37ºC for 24 hours. After 24 hours, the zone of inhibition was measured.
RESULTS AND DISCUSSION
In the present work, both aqueous and ethanolic extracts of fruit pulp and lyophilized powder were screened phytochemically for the presence of various classes of phytochemical constituents like carbohydrates, amino acids, proteins, tannins, steroids, alkaloids, terpenoids, glycosides, quinones, steroids and phenolic compounds following standard procedures.
The aqueous extract of both fruit pulp and lyophilized powder extract were rich in compounds as compared to ethanolic extract of fruit pulp. Ethanolic fruit pulp extract showed presence of moderate amount of alkaloids, saponins, phlobatannins and ethanolic extract of lyophilized powder revealed presence of moderate amount of carbohydrates, amino acids & proteins, saponins and flavonoids. However, quinones were absent in both the extracts.
The present study reveals that immense therapeutic potential exist in custard apple fruit extract which is attributed to the presence of alkaloids, flavonoids, tannins, phlobatannins, carbohydrate, amino acids, proteins, glycosides, saponins, steroids and phenolic compounds. In the present study lyophilized fruit extract of Annona squamosa showed good antimicrobial activity against gram positive and gram negative microorganisms as presented in Table 2.
The fruit extracts tested against gram positive bacteria showed higher zone of inhibition than those for gram negative bacteria. The zone of inhibition increased with increase in mass of fruit taken. Hence, the antimicrobial activity was found to be proportional to the quantity of fruit.
Another important finding of the present study points out to the activity of lyophilized Annona squamosa powder against most human pathogenic microorganisms. In this experiment the negative control used was 0.1% DMF which failed to show any anti microbial activity. The antimicrobial activity of lyophilized fruit extract was comparable to that of the standard drug Chloramphenicol (10 µg/disc), which further proved that Annona squamosa fruit has significant antimicrobial activity.
Table 1: Preliminary phytochemical screening of aqueous and ethanolic extract of Annona squamosa fruit
S. No. | Phytochemical Constituents | AEFP (Aqueous Extract of fruit pulp) | EEFP (Ethanolic Extract of fruit pulp) | AEFRP (Aqueous Extract of freeze dried powder) | EEFRP (Ethanolic Extract of freeze dried powder) |
| 1. | Carbohydrates | +++ | + | +++ | ++ |
| 2. | Amino acids & proteins | +++ | + | +++ | ++ |
| 3. | Alkaloids | +++ | ++ | +++ | + |
| 4. | Tannins | +++ | + | +++ | + |
| 5. | Saponins | +++ | ++ | +++ | ++ |
| 6. | Phlobatannins | +++ | ++ | +++ | + |
| 7. | Flavonoids | +++ | + | +++ | ++ |
| 8. | Terpenoids | +++ | + | +++ | + |
| 9. | Glycosides | +++ | + | +++ | + |
| 10. | Steroids | +++ | + | +++ | - |
| 11. | Quinones | - | - | - | - |
Legend: +++ indicates presence in good amount, ++ indicates presence, + indicates just presence and - indicates absence.
Table 2: Antibacterial activity of different concentration of Annona squamosa fruit extract against test microorganisms Sample size was taken for study: 1
Test Organism |
|
Zone of Inhibition (mm) |
|||||
Concentration of fruit Extracts |
Inhibition (%) |
Negative Control |
Positive Control |
||||
10mg |
20 mg |
30mg |
Fruit Extract |
100 µL DM |
(Chloramphenicol (10 µg/disc) |
||
Staphylococcus aureus |
10 |
14 |
16 |
22.15 |
Nil |
34 |
|
Streptococcus pyrogens |
15 |
17 |
20 |
41.66 |
Nil |
32 |
|
E. coli |
12 |
18 |
22 |
57.46 |
Nil |
26 |
|
Protease vulgaris |
12 |
15 |
17 |
39.643 |
Nil |
27 |
|
Vibrio cholera |
10 |
16 |
18 |
38.526 |
Nil |
29 |
|
Bacillus subtilus |
10 |
12 |
15 |
33.284 |
Nil |
26 |
|
Shigella dysentria |
5 |
8 |
10 |
18.904 |
Nil |
23 |
|
Klebsiella pneumonia |
7 |
13 |
16 |
22.15 |
Nil |
26 |
|
Pseudomonas aeruginosa |
8 |
14 |
18 |
51.84 |
Nil |
25 |
|
Salmonella typhi |
10 |
13 |
24 |
68.49 |
Nil |
29 |
|
Fig. 1: Represents Annona squamosa fruit extract having antimicrobial activity against tested microorganisms by agar well diffusion method. (A) E. coli (B) protease vulgaris
CD-Chloromophenicol- (10 µg/ disc), Control-0.1% DMF
Fig. 2: Represents Annona squamosa fruit extract having antimicrobial activity against tested microorganisms by agar well diffusion method C) Bacillus subtilus D) Pseudomonas aeruginosa
CONCLUSION
From the experimental data obtained in this present work, it is concluded that lyophilized Annona squamosa fruit extract showed significant antimicrobial activity against the pathogenic microorganisms. The phytochemical screening extract of lyophilized fruit powder revealed the presence of carbohydrates, Steroids, Saponins, amino acids, proteins, alkaloids, terpenoids, tannins, phlobatannins, flavonoids, and phenolic compounds. Further in-depth studies of this lyophilized fruit powder can lead to the development of human friendly antibacterial agents.
CONFLICT OF INTERESTS
Declared None
ACKNOWLEDGEMENT
The authors place on record, their deepest sense of gratitude to SASTRA University for providing necessary infrastructure to carry out this work.
REFERENCES